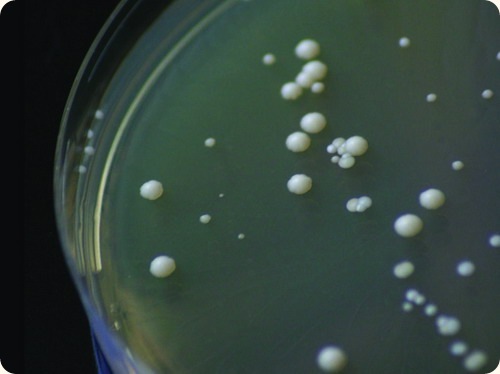
W020100916466384519104

根據最新一期的英國醫學期刊「刺胳針」報導,科學家認為,致命的禽流感H5N1病毒,會經由母體的胎盤傳染給未出生的胎兒。
根據最新一期的英國醫學期刊「刺胳針」報導,科學家認為,致命的禽流感H5N1病毒,會經由母體的胎盤傳染給未出生的胎兒。- 1月 25 週二 201113:25
研究:禽流感H5N1病毒可經由母親傳染給胎兒
 根據最新一期的英國醫學期刊「刺胳針」報導,科學家認為,致命的禽流感H5N1病毒,會經由母體的胎盤傳染給未出生的胎兒。
根據最新一期的英國醫學期刊「刺胳針」報導,科學家認為,致命的禽流感H5N1病毒,會經由母體的胎盤傳染給未出生的胎兒。- 1月 25 週二 201113:22
世界最高餐廳情調 杜拜開張
- 1月 25 週二 201113:19
中國「恐歸族」大增 在故鄉留守老人難過年
- 1月 25 週二 201112:37
彩券春節加碼 送百組百萬
- 1月 25 週二 201112:27
體操美女 戴菲菲 vv

戴菲菲 檔案資料姓名:戴菲菲生日:2月7日 part-time:演員,模特身份:北京大學本科生星座:水瓶座身高:175 夢想:環遊世界星座:水瓶座血型:AB 全國冠軍就拿了十多次的戴菲菲並沒有禁錮住自己的腳步,她的目標是世界冠軍。在2001年北京舉行的世界大學生運動會上,戴菲菲和隊友共同努力,一口氣拿下了兩個單項世界冠軍,分別是棒操和繩球的兩個世界冠軍。 現在是北大學生的戴菲菲,這位曾經的體操皇後還是一名演員還是一位頂級模特。
- 1月 25 週二 201102:55
研究稱進化過程中女性越來越美 男性沒變化
- 1月 25 週二 201102:50
人類為何開始直立行走?科學家稱因趴著太熱
- 1月 25 週二 201102:32
美培育出首個人造卵巢 可實現卵子體外發育

美培育首個人造卵巢可實現卵子體外發育 據國外媒體報道,美國科學家成功在實驗室培育出世界第一個人造卵巢,可用於讓人類卵子在體外發育成熟。這項突破將對生育研究產生重大影響。科學家表示,人造卵巢可幫助面臨化療或其他治療的女性保有生育能力。
美國布朗大學和婦嬰醫院的科學家利用該醫院正值生育年齡的患者捐獻的細胞培育出人造卵巢。在這些細胞長成蜂巢狀之後,人類卵子被植入這個結構的小洞內,幾天之後,細胞對卵子進行包膜,以模擬真實的卵巢。科學家面臨的一個考驗是,這個結構能否擁有與真實卵巢一樣的功能,讓卵子發育成熟。實驗中,科學家能夠讓卵子從“早期囊狀卵泡”階段步入完全成熟狀態。
科學家認為這種結構能夠回答有關健康卵巢如何工作的一系列基本問題,同時還可以充當一個測試臺,用於研究影響卵子成熟和健康的問題。在未來,人造卵巢還可以用於保持面臨癌症治療的女性生育能力。在接受放療或者化療前,醫生可以從患者體內提取不成熟的卵子並進行冷凍,而後借助人造卵巢讓卵子在患者體外發育成熟。
布朗大學沃倫·阿爾珀特醫學院產科學與婦科學教授桑德拉·卡森表示:“卵巢由3種類型的細胞構成,利用3種細胞係生成一個三維組織結構在歷史上還是第一次。這是一次全新的嘗試,也是第一次成功利用三維組織工程學手段讓卵母細胞在體外發育成熟。”研究成果刊登在《輔助生殖與遺傳學雜誌》上。
- 1月 25 週二 201102:27
研究人員發現:酵母世界中存在"善意"的謊言
如果每個人都很誠實,這個社會會運轉得更好嗎?那是你沒有碰上酵母。 一項發表在9月14日的《科學公共圖書館—生物學》上的研究表明,當這些單細胞真菌中的一些撒謊後,它們能夠刺激整個種群的生長。 酵母會分泌轉化酵素,這種酶能夠將蔗糖分解為果糖和葡萄糖,而後者正是酵母喜愛的食物。然而並不是所有的酵母都能夠分泌這種酶。 有的僅僅會啜食由其他酵母生產的葡萄糖,進而“欺騙”了種群。但是這種吃白食的行為實際上對於集體是有利的:那些有“騙子”的種群(如上圖)能夠比沒有“騙子”的種群多生長20%。這是緣于當周圍的酵母較少時,它們可以更有效地利用這些葡萄糖。因此通過吞食額外的葡萄糖,這些“騙子”幫了它們同伴一個忙。
- 1月 25 週二 201102:26
美黑白雙胞胎姐妹已上學 曾被稱百萬分之一奇跡





